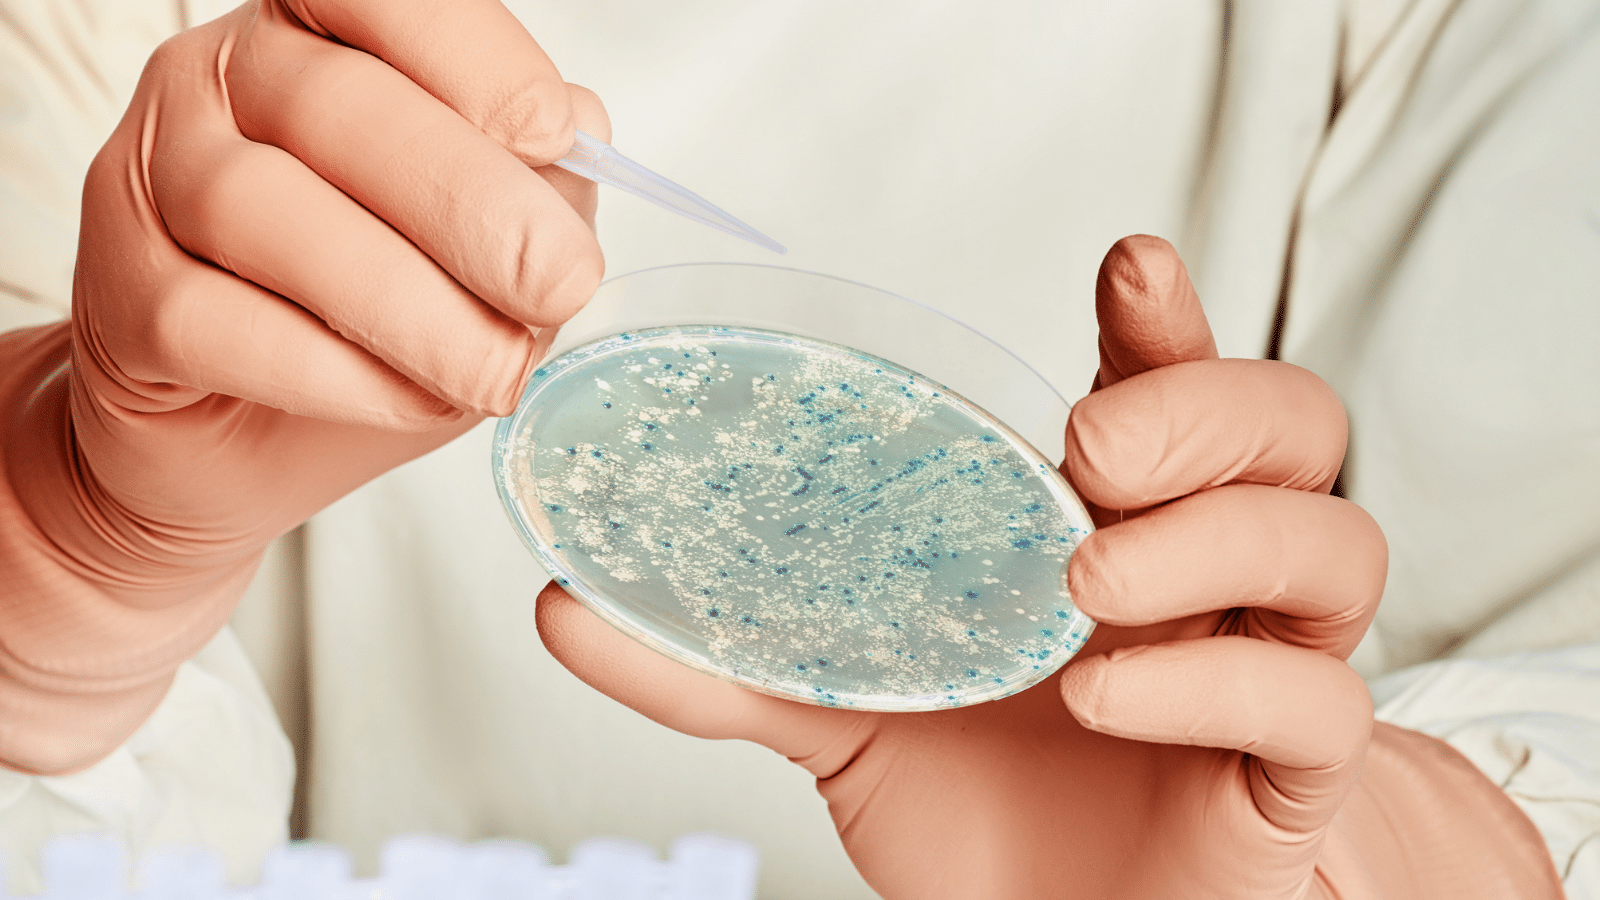
Entender los plásmidos: pequeñas moléculas con grandes implicaciones - Grupo QbD

Life Sciences Blog
Tanto si trabajas en farma, biotecnología, productos sanitarios u otro sector, nuestros servicios integrales y el asesoramiento de nuestros expertos están pensados para mantenerte informado y un paso por delante de las tendencias del sector. Explora nuestros contenidos y mantente al día de los últimos avances y mejores prácticas.
Life Sciences Blog


 No Items Found! Please Try Some Different Keywords
No Items Found! Please Try Some Different Keywords
























%20in%20Drug%20Products%20Understanding%20the%20New%20EMA%20Guideline%20Updates.jpg)


.jpg)





%20and%20Quality%20Risk%20Management%20(QRM)%20in%20ensuring%20pharmaceutical%20integrity%20%20QbD%20Group.jpg)



%20a%20key%20requirement%20in%20the%20new%20Annex%201.jpg)











%20simplified%20key%20requirements%20and%20best%20practices%20for%20compliance.jpg)
%20-%20QbD%20Group.jpg)




















.jpg)











.png)




















.jpg)
.png)










.png)
-2.png)
.png)
.png)


.png)
.png)


.jpg)

.png)

.png)













.png)



















.png)
























